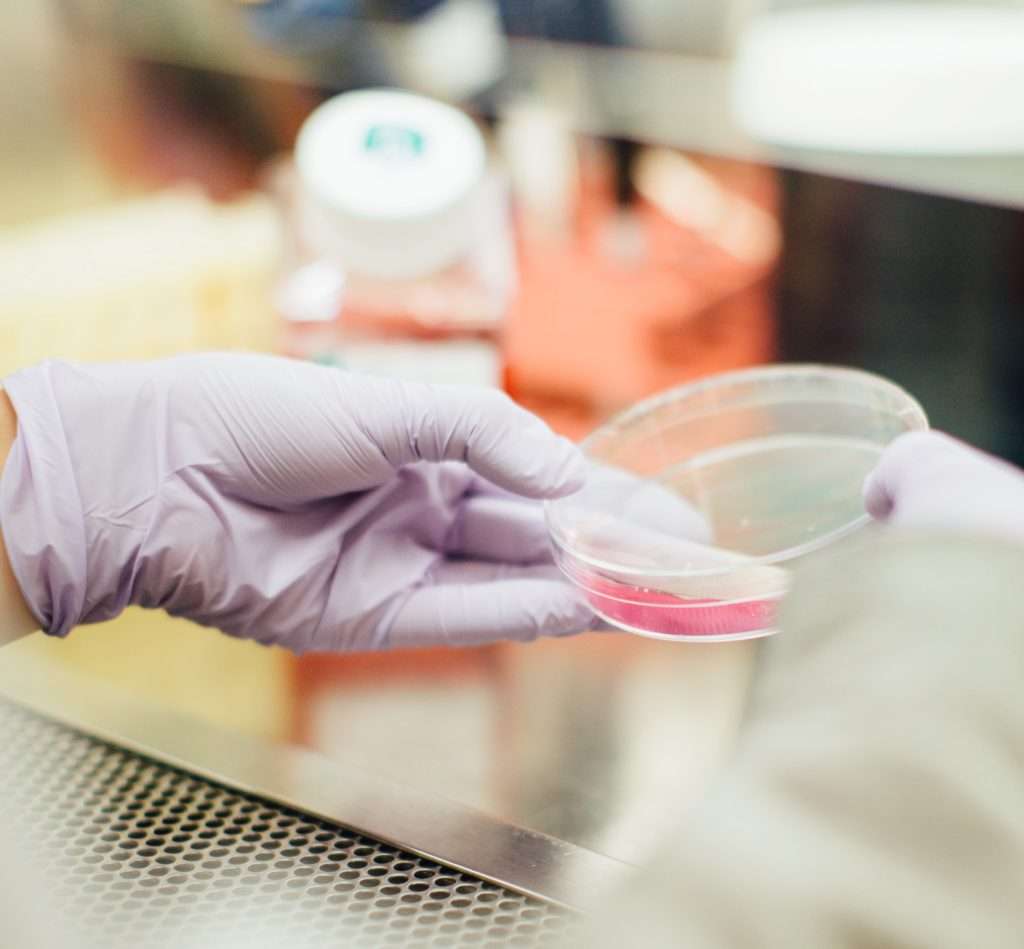

Régulièrement, les médecins demandent que des analyses médicales soient réalisées afin de mieux comprendre ce qui amène leurs patients à consulter. C’est a ce moment-là que les laboratoires d’analyses médicales entrent en scène. Les analyses, réalisées sur des échantillons prélevés au cabinet médical ou au laboratoire, révèlent notre état de santé a un instant donne, ce qui permet ensuite au médecin d’affiner son diagnostic, d’évaluer l’efficacité d’un traitement ou de surveiller l’évolution d’une maladie.
Par Adeline Beijns, Julie Kessler et Marie Nezan
Les tests effectués
Une équipe de coursiers se charge de faire, chaque jour, le tour des cabinets médicaux pour récupérer les échantillons et de faire les trajets supplémentaires pour assurer les analyses les plus urgentes. De leur côté, certains patients viennent directement au laboratoire pour faire leurs prises de sang ou déposer d’autres types d’échantillons, selon la demande du médecin. Les laborantins réceptionnent ces échantillons ; ils vérifient les données des patients et que les tubes de prélèvement correspondent aux analyses demandées.

Cette étape, la pré-analytique, est primordiale pour le bon traitement des échantillons. Ces derniers vont être répartis sur les différents secteurs du laboratoire : la chimie clinique (cholestérol, taux de fer, glycémie…), l’hématologie (anémie, leucémie), l’immunologie (maladies auto-immunes), la microbiologie (identification des pathogènes tels que les bactéries, les virus…), la pathologie (kystes bénins ou malins) et la génétique (maladies héréditaires).
Une étroite collaboration avec votre médecin
Des analyses de routine aux plus spécifiques, les laboratoires sont en mesure d’évaluer de nombreux paramètres de notre santé : taux d’hormones spécifiques (grossesse), de glucose dans le sang (diabète), les réserves de fer dans le sang (anémie), l’identification de germes responsables d’infections urinaires et beaucoup d’autres. La personne responsable du laboratoire est en charge de surveiller les résultats et de contacter le médecin traitant en cas de résultats pathologiques pour optimiser la prise en charge du patient.
La crise du coronavirus : défi relevé
Depuis les débuts de la crise du coronavirus, les laboratoires ont été fortement sollicités pour répondre
à la demande extrêmement forte et inattendue de tests COVID. Cet afflux d’analyses, combiné au manque de stock initial des fournisseurs, a parfois mené les laboratoires à une saturation ponctuelle de leurs capacités. Heureusement, ils ont réussi à s’organiser pour répondre aux besoins de la population avec l’installation de nouveaux systèmes, l’automation, l’engagement de personnel… Le tout, en maintenant toutes les autres analyses nécessaires au suivi de notre santé.

En cas de doute, n’hésitez pas à consulter votre médecin !
